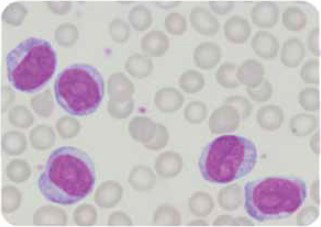
Enunciado 3417892-1

Em discussão de casos clínicos, os docentes do Setor de Onco Hematologia revelaram a clínica de uma paciente, 50 anos, que apresentava alterações na linhagem linfocítica. A imagem da lâmina do esfregaço de sangue periférico da paciente demonstrada a seguir acusou a presença das seguintes células:
Lâmina de esfregaço de sangue periférico:
(Imagem cedida pelo Laboratório de Análises Clínicas da FMABC)
Provas
Questão presente nas seguintes provas
Médico - Patologia Clínica/Medicina Laboratorial
50 Questões